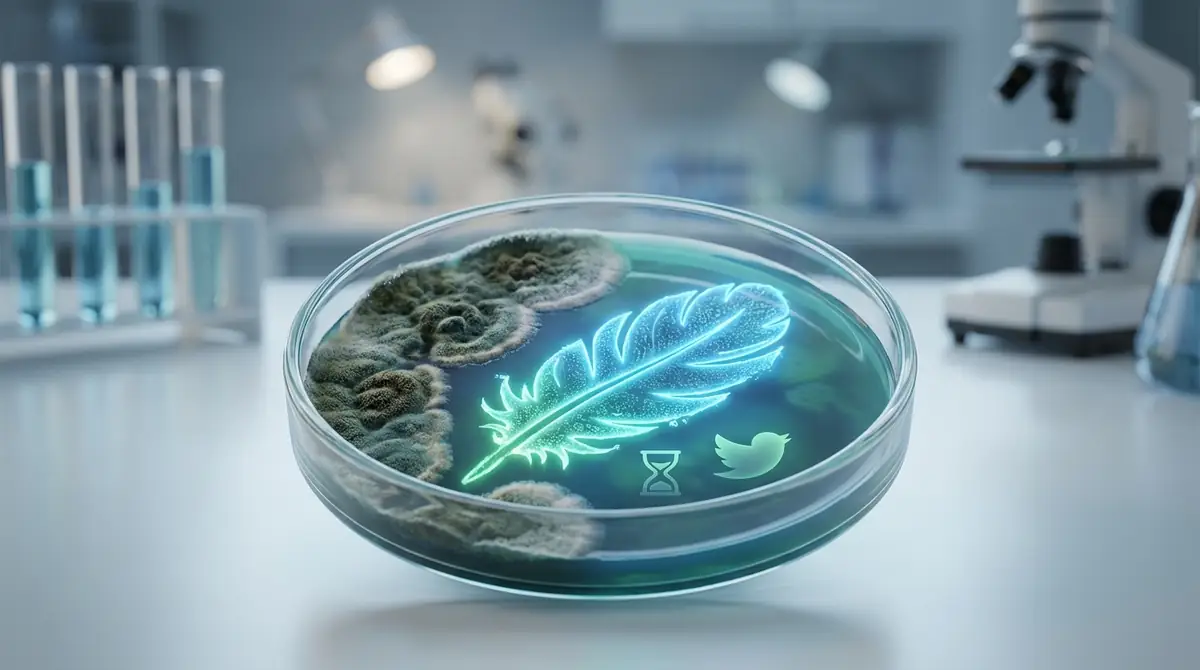
メガバクテリア症は完治する？寿命・致死率への影響

インコが吐く、黒っぽい便が出る、食べているのに痩せる。そんな変化があると、飼い主としては強い不安を感じますよね。メガバクテリア症は小鳥でよく問題になる消化器の感染症で、早期発見がとても重要です。この記事では、病気の正体から症状、治療、自宅ケア、予防のコツまでをわかりやすく整理して解説します。
メガバクテリア症とは?原因菌と感染経路の基礎知識

正式名称はAGY・マクロラブダス症|真菌(カビ)の一種
結論からいうと、メガバクテリア症は細菌の病気ではありません。
正式にはAGY、またはマクロラブダス症と呼ばれ、鳥の胃に感染する酵母様真菌によって起こる消化器疾患です。
昔は見た目が大きな細菌に見えたためメガバクテリアと呼ばれましたが、現在は真菌として扱われています。
感染部位は主に腺胃と筋胃のつなぎ目で、胃炎や潰瘍を起こし、消化不良や体重減少につながります。参考: アニコム損保 Kind動物病院
感染経路|親鳥からの垂直感染と糞便経由の水平感染
感染は主に、親鳥の吐き戻し給餌や、糞便や嘔吐物を介した口からの取り込みで広がります。
とくにヒナ期は親鳥から餌をもらう機会が多いため、糞便で汚染された環境や吐き戻し給餌を介した経口感染が疑われますが、垂直感染と断定するのは適切ではありません。
さらに、無症状でも病原体を含む便を排泄する潜伏感染個体がいるため、見た目が元気でも同居鳥へ広がる可能性があります。
そのため、多頭飼いではケージ共有、止まり木の共用、吐き戻し汚染の放置が感染拡大のきっかけになりやすいです。参考: アニコム損保 おがわ動物病院
かかりやすい鳥種|セキセイインコ・オカメインコに多い理由
もっとも注意したいのはセキセイインコで、次いでオカメインコなどの小型鳥でもよくみられます。
有病率は地域や検査法で大きく異なり、セキセイインコでは10〜65%程度と幅があり、オカメインコも一研究で26.9%など報告にばらつきがあります。国内で一律に25%、10%と断定するのは適切ではありません。
また、別の解説ではセキセイインコは保有率がさらに高いとされ、無症状キャリアの多さが発症機会の多さにつながると考えられます。
若齢、ストレス、換羽、他疾患などで免疫が落ちると、持っているだけの状態から発症しやすくなります。参考: Kind動物病院 横浜エキゾチック動物病院
人間や他のペットにうつる?感染リスクの真実
飼い主が最も気にする点ですが、公開されている一般向け解説では、問題の中心は鳥から鳥への感染として説明されています。
つまり、家庭で優先すべき対策は人への過度な不安より、同居鳥の隔離、糞便や嘔吐物の速やかな清掃、食器の分離です。
犬や猫など他のペットへの感染を主題にした記載は少なく、実務的には鳥同士の感染管理を徹底することが重要と考えておくとよいでしょう。
ただし、衛生管理はどの病鳥でも基本です。清掃後の手洗い、器具の洗浄、ケージ周辺の乾燥維持は続けてください。参考: アニコム損保 みらい動物病院
メガバクテリア症の症状|初期〜進行時のサインを見逃さない

初期症状|食欲低下・体重減少・軽い嘔吐
初期に最も見逃されやすいのは、食べているのに痩せるという変化です。
ほかにも、食欲の波、軽い吐出や嘔吐、便の形の乱れ、元気の低下など、はっきりしない不調から始まることがあります。
体重は見た目だけでは判断しにくく、毎日数グラムの減少でも小鳥には大きな変化です。
とくにセキセイインコでは30〜35g前後が一般的な個体でも、30gを切ると警戒が必要とする臨床現場の目安があります。参考: 横浜エキゾチック動物病院 吉田動物病院
進行時の症状|黒色便・頻繁な嘔吐・急激な衰弱
病気が進むと、黒色便、未消化便、頻回の嘔吐、急激な体重低下など、明らかな消化器症状が目立ってきます。
さらに、羽毛をふくらませる、止まり木でじっとする、脱水気味になる、便が酸っぱい臭いになるなど、全身状態の悪化もみられます。
進行例では衰弱死の危険もあり、慢性化すると胃が不可逆的に傷み、菌が減っても症状だけ残ることがあります。
黒色便や食べられない状態があるなら、自宅で様子を見る時間は長くありません。参考: さくら白井動物病院 横浜エキゾチック動物病院
【症状チェックリスト】今すぐ確認すべき5つのポイント
自宅での確認は、毎日同じ時間に同じ順番で行うと変化に気づきやすくなります。
毎朝の体重が前日より落ちていないか食べている量に対して痩せていないか嘔吐や吐き戻しが増えていないか黒色便や未消化便が出ていないか羽をふくらませて動かない時間が長くないか
この5項目のうち2つ以上が当てはまるなら、家庭判断で長く待たずに鳥を診られる病院へ相談するのが安全です。
記録は紙でもスマホでも構いません。体重、便、食欲をセットで残すと診断に役立ちます。参考: 吉田動物病院 アニコム損保
メガバクテリア症は完治する?寿命・致死率への影響
完治の可否|菌の根絶は難しいが症状コントロールは可能
結論として、症状の改善や寛解は期待できますが、菌の完全排除は難しく、再発や再排菌が起こりうる病気として理解するのが現実的です。
早期治療で菌が検出されなくなる例はある一方、少量が残って無症状で共存したり、環境変化で再増殖したりすることがあります。
そのため、治療の目標は菌を減らすだけでなく、胃のダメージを抑え、体重と食欲を安定させることにあります。
治療後に元気でも、再検査と生活管理を続けることが再発予防の鍵です。 参考: さくら白井動物病院 おがわ動物病院
寿命への影響|早期発見なら普通の生活も可能
寿命への影響は、発見の早さと胃の障害の深さで大きく変わります。
初期段階で見つかり、数週間から数か月の治療で安定すれば、その後も普段に近い生活を送れる子は少なくありません。
一方で、長く気づかれず慢性化したケースでは、胃の機能低下が残り、食事管理や再発監視が生涯必要になることがあります。
寿命を守るうえで最も大切なのは、症状が軽いうちに受診し、体重減少を止めることです。参考: Kind動物病院 横浜エキゾチック動物病院
致死率と死亡リスク|進行すると危険な理由
数値として一律の致死率を示すのは難しいものの、進行例では命に関わる病気です。
理由は、胃炎や潰瘍で十分に栄養を吸収できず、嘔吐や消化不良が続くことで短期間に体力を失いやすいためです。
小鳥は体重が数グラム落ちるだけでも危険域に近づきます。20g台前半まで落ちるセキセイインコは重篤と考えるべきケースがあります。
黒色便、頻回嘔吐、食べられない、動けないがそろったら、その日の受診を前提に動いてください。参考: 横浜エキゾチック動物病院 吉田動物病院
メガバクテリア症の治療法|検査から投薬までの流れ

動物病院での検査方法|糞便検査・そのう検査
診断の基本は糞便検査で、顕微鏡で細長い菌体を直接確認します。
必要に応じてそのう液検査を組み合わせ、症状や体重減少の経過も含めて総合判断します。
ただし、菌は毎回必ず排泄されるわけではなく、低数または間欠的にしか排泄されないことがあるため、1回の糞便検査が陰性でも否定できません。
疑わしいのに見つからない場合は、複数回検査やPCRが補助的に使われることもあります。参考: 横浜エキゾチック動物病院 Kind動物病院
治療に使われる薬|抗真菌薬の種類と効果
治療の中心は抗真菌薬です。
一般的には経口投与が基本で、病院解説ではアムホテリシンBが代表薬として紹介されています。
症状に応じて、胃薬、吐き気止め、抗生剤、流動食、皮下点滴などが併用され、重症例では入院が必要になることもあります。
薬だけでなく、栄養と保温を同時に整えることが回復速度に直結します。 参考: Kind動物病院 おがわ動物病院
治療期間の目安|最低4週間〜数ヶ月かかることも
治療は短期間で終わらないことが多く、少なくとも数週間はみておく必要があります。
報告される投薬期間には幅があり、アムホテリシンBでは14日、28〜30日、10〜30日などのレジメンが文献で示されています。重症例ではより長い管理が必要なこともありますが、6〜8週間を一般的と断定するのは避けたほうが正確です。
初期なら数週間で落ち着くケースもありますが、慢性化していると菌が減っても症状改善に時間がかかります。
症状が消えた時点で自己判断でやめず、再検査で確認してから終了するのが基本です。参考: Kind動物病院 おがわ動物病院
【緊急度別】病院に行くべきタイミング判断フロー
迷ったら、体重減少の速さと食べられているかで判断します。
今すぐ受診 黒色便、繰り返す嘔吐、食べない、ぐったり、止まり木に安定して乗れない。24時間以内に相談 食べているのに痩せる、未消化便、羽をふくらませる時間が増えた。数日以内に検査予約 無症状でも同居鳥が陽性、新しく迎えた子、健康診断で要確認。
夜間で受診まで時間が空く場合は、まず保温と静養を優先し、無理な給餌や独断の投薬は避けてください。
とくに黒色便と急減量は危険信号です。参考: 吉田動物病院 横浜エキゾチック動物病院
メガバクテリア症の自宅ケア|治療中に飼い主ができること

保温管理|病鳥に適した温度と保温方法
自宅ケアで最優先なのは保温です。
公開情報では、体調不良時の目安として室温28〜30℃程度が勧められており、ケージの一部を暖かく保てるようにします。
ペットヒーターや保温電球を使う場合も、ケージ全体を同じ温度にせず、鳥が自分で移動して調整できる余地を残すのが大切です。
急な温度変化、夜間の冷え込み、風の通り道は回復を妨げるため避けてください。参考: 吉田動物病院
食事の工夫|消化に優しい与え方と栄養管理
食事は量より吸収しやすさが重要です。
嘔吐や未消化便がある時は、獣医師の指示のもとで流動食や総合栄養食のペレットを活用し、胃への負担を減らします。
体重が落ちている子は、少量を複数回に分けて与えるほうが安定しやすく、食べた量と便の変化を一緒に記録すると役立ちます。
自己流のサプリ追加より、まずは十分な摂食量と水分確保を優先してください。参考: 吉田動物病院 Kind動物病院
投薬のコツ|嫌がる鳥への薬の飲ませ方
薬を確実に入れることは、再発予防を含めて非常に大切です。
基本は病院で教わった方法を守り、シリンジ投与の角度や量を自己流で変えないことが安全です。
嫌がる子でも、保定は短時間で終える、投薬後は安静にする、成功したらすぐ静かな環境に戻す、という流れにすると負担を減らせます。
飲み残しや吐き戻しが続くなら、薬の種類や与え方の再相談が必要です。参考: おがわ動物病院
多頭飼いの隔離と感染予防|他の鳥を守る方法
多頭飼いでは、陽性鳥の隔離が最も重要です。
ケージ、食器、水入れ、止まり木、掃除道具は分け、糞便や吐き戻しが他の鳥の口に入らない管理を徹底します。
新しい鳥を迎えた直後や、同居鳥が陽性になった時は、見た目が元気でも検査結果が出るまでは別室管理が安全です。
感染予防は消毒だけでなく、接触機会そのものを減らす発想が大切です。 参考: おがわ動物病院 吉田動物病院
メガバクテリア症の治療費と病院の探し方

鳥を診られる専門病院を見つけるポイント
病院選びでは、犬猫中心ではなく鳥の診療経験があるかを最優先にしてください。
確認したいのは、糞便検査やそのう検査に対応できるか、入院や補助給餌が可能か、再検査を含めた継続診療に慣れているかの3点です。
予約前に、鳥の初診受付時間、急変時の相談可否、持参すべき便や体重記録の有無も聞いておくとスムーズです。
迷ったら、普段から鳥の健康診断を案内している病院を候補にすると失敗しにくいです。参考: 横浜エキゾチック動物病院 吉田動物病院
治療費の目安|初診から治療完了までの費用
治療費は病院と重症度で差が大きいものの、目安を知っておくと通院計画が立てやすくなります。
項目目安初診料1,500〜3,000円前後糞便・そのう検査2,000〜5,000円前後再診と投薬1回3,000〜8,000円前後重症時の補助治療1万円以上になることも
数週間から数か月の通院になると、総額は2万〜7万円以上になるケースもあります。
ただし、早期発見ほど入院や補助治療を避けやすく、結果的に費用を抑えやすい傾向があります。
メガバクテリア症の予防法|発症リスクを下げる日常管理

新しい鳥を迎えるときの検疫と健康診断
予防の第一歩は、お迎え直後の隔離と検査です。
メガバクテリア症は見た目が元気でも持っていることがあるため、新入りの鳥は早めに糞便検査を受け、結果が出るまで同居を避けます。
1回の検査で陰性でも見逃すことがあるので、必要に応じて複数回の確認が勧められます。
多頭飼い家庭ほど、この検疫の有無がその後の感染拡大を左右します。参考: おがわ動物病院 吉田動物病院
ストレス軽減と免疫力を高める飼育環境
発症予防では、菌を持たせないこと以上に、発症させない環境作りが重要です。
寒冷、換羽期の栄養不足、過密飼育、急な模様替え、睡眠不足などは免疫低下の引き金になり、潜伏感染からの発症を招きます。
毎日同じ明暗リズム、安定した室温、十分な休息、清潔な食器と水を保つことで、再発予防にもつながります。
元気な時期こそ環境の乱れを減らすことが、最も実践的な予防法です。参考: 吉田動物病院 アニコム損保
定期的な体重測定と糞の観察で早期発見
最も効果的な早期発見法は、毎日の体重測定です。
小鳥は不調を隠しやすいため、見た目が元気でも体重は先に落ちることがあります。
加えて、糞の色、形、未消化粒の有無、吐き戻しの回数を観察すれば、受診のタイミングを逃しにくくなります。
健康診断の糞便検査を定期的に受けることも、潜伏感染の把握に役立ちます。参考: 横浜エキゾチック動物病院 吉田動物病院
メガバクテリア症に関するよくある質問

メガバクテリア症は治りますか?
Q. メガバクテリア症は治りますか? A: 早期に治療できれば、菌が検出されなくなるほど回復する例はあります。 ただし再発しやすいため、治療終了後も体重測定と再検査を続けることが大切です。参考: おがわ動物病院
感染しても発症しないことはありますか?
Q. 感染しても発症しないことはありますか? A: あります。 無症状の潜伏感染は珍しくなく、健康な状態では症状が出ない子もいます。 ただし、ストレスや他の病気で免疫が落ちると発症することがあります。参考: アニコム損保
一度治っても再発しますか?
Q. 一度治っても再発しますか? A: 再発はありえます。 ストレス、発情、環境変化、別の病気などをきっかけに再増殖することがあるため、治療後も飼育環境の安定が重要です。参考: さくら白井動物病院
治療中に他の鳥と同居させても大丈夫?
Q. 治療中に他の鳥と同居させても大丈夫? A: 基本的にはおすすめできません。 糞便や嘔吐物で広がるため、少なくとも検査が安定するまではケージや食器を分け、できれば別室で管理するほうが安全です。参考: おがわ動物病院
まとめ|早期発見と適切な治療で愛鳥を守ろう

メガバクテリア症は珍しい病気ではありませんが、早く気づければ十分に対処できる可能性があります。
メガバクテリア症は細菌ではなく真菌による胃の感染症食べているのに痩せる、嘔吐、黒色便は重要サイン診断は糞便検査が基本で、陰性でも再検査が必要なことがある治療は抗真菌薬に加え、保温と栄養管理が重要多頭飼いでは隔離とお迎え後の健康診断が予防の要
少しでも気になる症状があるなら、今日から体重測定と便の観察を始め、鳥を診られる病院へ早めに相談してください。参考: 横浜エキゾチック動物病院 アニコム損保


コメント